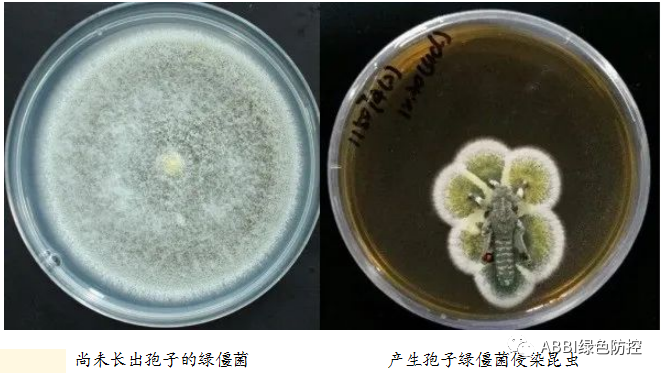
图片

绿僵菌属(Metarhizium)真菌是一种具有较强致病性的麦角菌科异虫草属昆虫病原真菌,该属菌株可寄生于约8个目、42个科,共200多种昆虫、螨类和线虫体内。据报道,目前已有13种绿僵菌,包括金龟子绿僵菌(M. anisopliae)、贵州绿僵菌(M.guizhouense)、黄绿绿僵菌(M. flavoviride Gams&. Rozsypal)、白色绿僵菌(M.ablum)、棕色绿僵菌(M. brunneum)、平沙绿僵菌(M.pingshaense)、柱孢绿僵菌(M. cylindrosporum)、翠绿绿僵菌(M.iadini)、大孢绿僵菌(M. majus)、蝗绿僵菌(M.acridum)、耐寒绿僵菌(M. frigidum)、鳞翅目绿僵菌(M.lepidiotae)和球孢绿僵菌(M. globosum)。

绿僵菌具有分布范围广、杀虫、对人畜农作物无毒害等特点,被制成粉剂、干菌丝、混合剂及无纺布菌条等形式的真菌生防制剂,用于农业、林业害虫的生物防治,防治效果极佳,具有很高的生态应用价值和经济应用价值。绿僵菌的发现
最早发现绿僵菌的是梅契尼科夫(Metschnikoff),他在1879年观察到一批死亡的金龟子在昆虫死后两天,从它们身上生出菌丝,尤其显著的是菌丝环绕着气门的周围,菌丝初为白色,随后变为绿色,最后呈暗绿色。随后,Sorokin(1883年)根据梅契尼科夫确定的金龟子虫霉(Entomophthora anisopiae Metsch.)转属建立了绿僵菌属(Metarhizium)。绿僵菌可从金龟子、梨虎幼虫、叶蝉等昆虫尸体中分离获得。自绿僵菌建属以来,相继发现42个新种和变种。最早的绿僵菌应用是Metchnikoff在1880年尝试应用并取得成功,这使生物防护中生物防治制剂开始以病原真菌作为原材料。绿僵菌的侵染机理及生防机制是什么?
绿僵菌对寄主的入侵是寄主与病原菌之间的生理生化作用的综合结果。目前绿僵菌对昆虫寄主的侵染过程已基本清晰,首先是分生孢子附着在昆虫体表,孢子萌发后产生入侵菌丝并穿过体壁在及主体内大量繁殖,同时产生毒素并形成圆筒状孢子,最终导致寄主死亡。在侵染过程中绿僵菌分泌多种酶(如蛋白酶、几丁质酶、脂酶等),形成特殊结构(如附着胞、穿透钉、穿透菌丝等),并克服昆虫体表某些物质的抑制作用及昆虫体内的一系列免疫活动。
总体来说,绿僵菌的侵染过程主要分为以下几个阶段:孢子萌发、穿透虫体、体内发育和致死。孢子萌发
分生孢子黏附于寄主表皮后,受体表有关活性物质的刺激而萌发产生芽管,芽管的生长对表皮具有很强的影响性。目前有部分研究认为,芽管可依靠菌丝先端分泌的黏液黏附在寄主上表皮表面,经过螺旋式伸长,寻找合适侵染点,并进一步分化产生穿透钉。例如氨基酸、蛋白质、糖类、类脂等一般的营养物就能使金龟子绿僵菌分生孢子发芽。穿透虫体
绿僵菌在附着胞形成期间可产生大量的胞内蛋白酶,通过酶解作用使得附着胞下面蜡层消失,促进穿透钉通过机械作用挤入上表皮。Butt(1988)的研究表明此过程寄主也将引发免疫反应,包括体壁障碍、体表短链脂肪酸如辛酸、奎酸的抑制作用、血细胞和血淋巴的应急机制等。体内发育和致死:
绿僵菌穿透昆虫体壁后即在昆虫体内发育,生长过程中会产生一系列环状六肽毒素即绿僵菌素,作为免疫抑制因子能够限制和削弱寄主的防御反应,最终导致昆虫死亡。
为什么开发绿僵菌生防制剂?
近年来,因为化学农药的大量使用,导致部分昆虫抗药性明显增强,持续的加大药量形成恶性循环,甚至达到无药可用的局面,从而食品和药材安全问题、环境保护问题倍受重视,使得生防制剂的研发及推广应用更加刻不容缓。绿僵菌对环境、土壤无污染,对人、畜、农作物无毒,是减少农药残留、降低环境污染、发展绿色农业的环保型药剂。另外,绿僵菌通过寄生杀灭害虫,不会产生抗药性问题。在适宜的温度条件下,绿僵菌还能不断繁殖,持续感染并杀灭地下害虫,是一种持效期长的真菌活体杀虫剂。因此,绿僵菌以其极具优势的作用机理与功能,是解决农药抗药性、降低农药使用量,保障农产品安全的有效途径之一。绿僵菌产业化现状
近五年我国新农药登记的数量,生物农药成为创新的主体。2022年获得登记的新品种5个,全部为微生物农药。生物农药作为综合防治的重要措施,在重大病虫害绿色防控中发挥作用越来越大。总体上看,生产品种比较集中,其中苏云金杆菌、枯草芽孢杆菌、木霉菌、未霉酸、苦参碱、阿维菌素等产品广泛应用。微生物农药产量居前的5个品种分别是:苏云金杆菌、枯草芽孢杆菌、棉铃虫核型多角体病毒、金龟子绿僵菌COMa421和多粘类芽孢杆菌KN-03,约占微生物农药产量的75%。真菌类生物农药的占比小。绿僵菌生防制剂的生产普遍以大米、米糠和稻壳为固体载体。绿僵菌产生分生孢子的方式有液体深层发酵(生产菌丝体)、固体发酵(生产真菌孢子)及液固双相发酵工艺,液固双相发酵综合了前两者的优势:(3)确保接种菌液对固体颗粒物质的均匀覆盖,使菌体能同步生长。以绿僵菌为原料的真菌生防制剂剂型主要有粉剂、可湿性粉剂、混合剂等类型,开发成真菌类生物制剂产品用于作物虫害防治。具有环保无污染、高效低成本且不易使害虫产生抗药性等潜在优势。
[国内登记情况]
经中国农药信息网查询,截止目前(2023年5月),金龟子绿僵菌在国内共有18个登记产品,其中有3个卫生用药,用于防治蜚蠊。具体登记情况见下表:

绿僵菌产品剂型方面的优劣
粉剂,由原药、填料(或载体)和少量其他助剂混合、粉碎、再混合等工艺过程而制成的具有一定细度的粉状制剂。
优缺点:不够环保、稳定性差、容易造成粉尘污染,用量逐渐减少。
可湿性粉剂,是含有原药、填料或载体、润湿剂、分散剂以及其他辅助剂,经混合、粉碎工艺达到一定细度的粉状剂型。可湿性粉剂加水搅拌可形成稳定、分散性良好的悬浊液,供喷雾使用。标准:达到98%通过325目筛,润湿时间小雨2分钟,悬浮率60%以上。
优缺点:节省有机溶剂,展着好,包装储运方便,稳定性有待提高,持效期短,易产生药害。
颗粒剂由原药、载体和少量其他助剂通过混合、造粒工艺而制成的松散颗粒状剂型。剂粒的有效成分含量在1%~20%之间,一般供直接撒施使用。
优缺点:方便撒施,粒剂稳定较差。
油悬浮剂,是由原药与适宜的助剂制成的稳定的非水悬浮剂,其中至少有一种成分不溶于非水介质,久置后允许有少量分层, 轻微摇动或搅动应是均匀、可以使用的。
优缺点:储藏和防效稳定,但必须超低容量喷雾,使用受限。
可分散油悬浮剂,有效成分以固体微粒分散在非水介质中形成的稳定的悬浮液体制剂。其有以下两大特点:
一是使用植物油、矿物油等分散介质,具有安全、环保的特点;
二是具有保护有效成分、减少雾滴飘移、提高雾滴在作物表面的黏附性、渗透性及润湿展布性等性能,最终使药剂的防治效果有一定的提升,利于提高农药利用率。
优缺点:提高药物在作物表面的粘附性、润湿性、渗透性,相比于乳油等剂型可分散油悬浮剂易燃易爆风险低,对环境污染小。
绿僵菌产业发展的瓶颈及技术突破
近些年随着国家政策鼓励,绿僵菌产业取得了一定的发展,但是仍有相关因素制约着该产业的发展,笔者整理如下:
◎产品方面:产品效果不稳定、货架期短、价格高、使用技术要求高。
◎生产发面:缺乏大规模纯菌固态发酵技术,缺乏投资,产品生产工业化动力欠缺。
◎研发方面:缺乏在生产条件下的生产、储藏、制剂关键技术研发。
◎应用技术:未充分利用真菌的作用特点,开发具体产品在不同环境下不同作物上与其他药剂的应用技术。
为解决以上问题,创制“理想”农用微生物制剂(活体微生物农药、微生物菌剂(肥)等)将成为持续发展绿僵菌有效途径。“理想”农用微生物制剂产品应具有如下特点:
◎广谱:一药多防--防控多种病虫,涵盖全生育期。
◎持效:药效期长--无抗性、能繁殖、保护天敌。
◎多功能:一菌多效--防控病虫、促进生长等。
◎改良土壤:结构功能--松土、解毒、释放营养、抑害促益。
开发创制“理想”农用微生物制剂新思路:
1.菌株分子设计育种:打造农用微生物产业的高端芯片
◎发掘重大性状功能基因及功能物质的调控网络
(杀虫、杀菌、杀线、除草、促生、抗逆和产孢等)。
◎构建无外源DNA的转化体系。
◎发掘基因调控元件。
◎构建表达害虫靶标基因dsRNA的工程菌。
2.研制高效稳定制剂
◎耐短时高温(运输)制剂。
◎高抗杂菌的真菌制剂。
◎种子处理剂。
3.开发高效稳定施药技术
◎无人机超低容量施药技术。
◎生防微生物原位扩繁技术。
笔者认为,农用微生物领域发展仍需要政策引导、资金支持,持续加大研发和产业化方面的研究力度,突破相关核心技术,打破瓶颈,开发出性价比更高,防效更好,使用更便捷的微生物制剂(农药、肥料等),秉承“预防为主”的设计开发理念,合理结合化学药剂的使用,助力全球农业高质量发展。